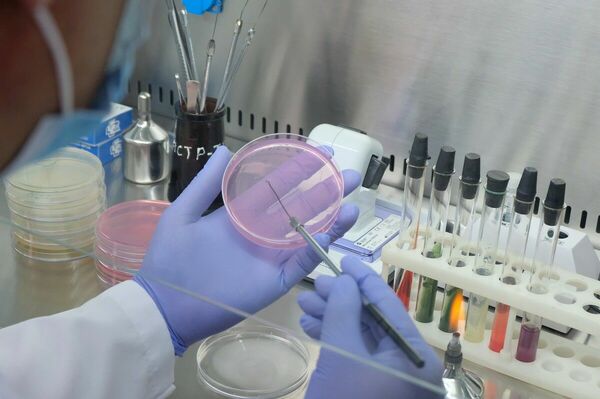
Мозговой шторм

Хочу сказать!
Хочу сказать!
Динара КУСАИН: Одна беда на всех
Снова дети выпали из окна: двое в Атырау и Алматы, один в Уральске. И опять мнения разделились. Одни требуют ужесточить наказание родителям за недосмотр, другие считают, что они и так уже наказаны. Я уверена в том, что карательные меры в этом деле помогут меньше всего.
У кого что болит
У кого что болит